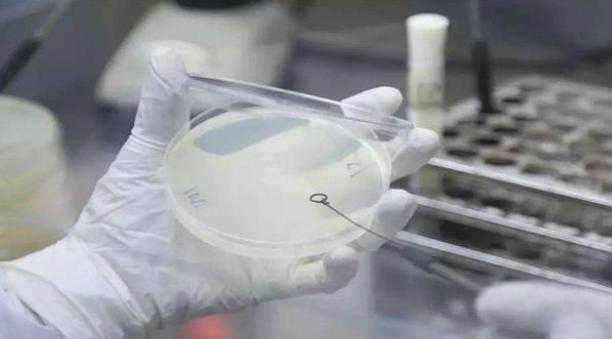

导读:本篇文章由网友(兔牙萝莉),通过网络收集整理的关于“华裔女科学家发现可以吃的塑料,人类污染有救了吗?(地球污染)”的相关信息,让我们一起来看看详细内容吧!
地球污染正在一步步的向好发展
一直以来我们地球上的塑料污染都是让科学家们非常头疼的一个问题,现在我们基本上生活当中每一天都需要用到塑料才可以。要知道我们现在地球上的污染是非常严重的,尤其是塑料污染,这些塑料在处理的时候,要么会损害土地,要么会损害空气或者海洋,不管怎么处理都是错的,偏偏在人类还离不开他,就算是人类,现在已经想出了相对比较可靠的办法,可是已经造成的污染已经非常严重了。

科学家在这么多年的过程当中也是对于白色污染做出了很多解决办法,可都是收效甚微。可是在前一段时间居然有一个华裔女科学家发现了一个处理白色垃圾的很好方式,用这种方式就是可以让生活当中的白色垃圾被解决掉,这和一些细菌有关系,他也是在做实验的过程当中偶然发现一个白色塑料上面沾满了细菌,然后这些塑料就被细菌给吃完了,然后最后这些细菌也是可以把塑料给换成二氧化碳和水,除此之外也没有了其他的有害物质。
要知道和二氧化碳相比,塑料所产生的其他危害可是要大的多,要是仅仅只是能够把塑料可以转化成二氧化碳,人类还是有很多办法可以解决的。只不过现在这个东西还在研究的过程,当并不能够投入使用,相信有了科学家的大力发展,在未来就有希望能够解决白色污染。

人类现在也慢慢的开始对于环境污染注重了起来,我国也早就开始了对于环境保护的提倡,按照现在的情况来看,应该已经有了不错的效果。